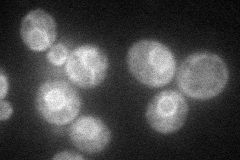

View description
C-22 sterol desaturase, a cytochrome P450 enzyme that catalyzes the formation of the C-22(23) double bond in the sterol side chain in ergosterol biosynthesis; may be a target of azole antifungal drugs
Localization:
Intensity:
Fold change:
Significance:
-
C’ GFP library in SD

ER91.07 -
N' NOP1pr-GFP in SD
ER50.7352 -
N' TEF2pr-mCherry in SD

ER35.1943 -
N' NATIVEpr-GFP in SD

ER59.878 -
N' TEF2pr-VC and Cyto-VN in SD

below threshold23.9416 -
C’ GFP library in SD+DTT

ER82.90.91No -
C’ GFP library in SD+H2O2

ER81.360.89No -
C’ GFP library in Starvation Media

ER34.440.37Yes -
C’ GFP library on the background of Pup2-DaMP

ER -
C’ GFP library on the background of CCT mutant

ER101.1171.11025No
